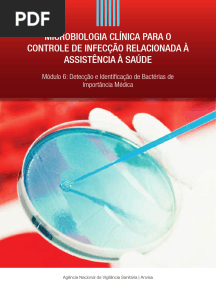

function cn(e,t){var n=e+t;return n<=0?0:Math.round(e/n*100)}% acharam este documento útil
Carregando

Modulo 6 Deteccao e Identificacao de Bacterias de Importancia Medica
Adicionado por Vilma Costa

Letramentos Multiplos Uma Nova Perspecti
Adicionado por Vilma Costa

OrientaçãoTécnica Internacional Sobre Educação em Sexualidadepdf
Adicionado por Vilma Costa

Educacao Nao Formal Participacao Da Sociedade Civil e Estruturas Colegiadas Nas
Adicionado por Vilma Costa